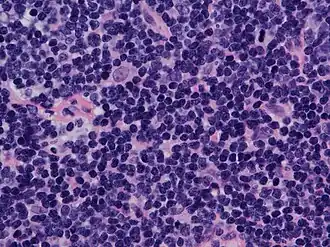

Linfoma não Hodgkin
| Linfoma não Hodgkin | |
|---|---|
| Sinónimos | Doença não Hodgkin |
![]() | |
| Linfoma de células do manto, um tipo de linfoma não Hodgkin, onde se observa os contornos irregulares do núcleo das células do linfoma | |
| Especialidade | Hematologia e oncologia |
| Sintomas | Aumento dos gânglios linfáticos, febre, suores noturnos, perda de peso, cansaço, prurido[1] |
| Início habitual | 65–75 anos de idade[2] |
| Fatores de risco | Imunodeficiência, doenças autoimunes, infeção por Helicobacter pylori, hepatite C, obesidade, vírus Epstein-Barr[1][3] |
| Método de diagnóstico | Biópsia dos gânglios linfáticos ou da medula óssea[1] |
| Tratamento | Quimioterapia, radioterapia, imunoterapia, terapia dirigida, transplante de células estaminais hematopoiéticas, cirurgia, vigilância[1] |
| Prognóstico | Taxa de sobrevivência a 5 anos: 71% (EUA)[2] |
| Frequência | 4,3 milhões (afetados durante 2015)[4] |
| Mortes | 231 400 (2015)[5] |
| Classificação e recursos externos | |
| CID-11 | XH50P3 |
| CID-10 | C82 a C85 |
| CID-9 | 200, 202 |
| CID-CID-O | 9591/3 |
| OMIM | 605027 |
| DiseasesDB | 9065 |
| MedlinePlus | 000581 |
| eMedicine | med/1363 ped/1343 |
| MeSH | D008228 |
Linfoma não Hodgkin é um grupo de cancros do sangue, do qual fazem parte todos os tipos de linfoma exceto o linfoma de Hodgkin.[1] Os sintomas mais comuns são gânglios linfáticos aumentados, febre, suores noturnos, perda de peso e fadiga.[1] Entre outros possíveis sintomas estão dores nos ossos, dor no peito ou prurido.[1] Alguns tipos são de crescimento lento, enquanto outros são de crescimento rápido.[1]
Os linfomas são tipos de cancro que se formam a partir dos linfócitos, um tipo de leucócitos (também denominados glóbulos brancos).[2] Os fatores de risco incluem imunodeficiência, doenças autoimunes, infeção pela bactéria Helicobacter pylori, hepatite C, obesidade e infeção pelo vírus Epstein-Barr.[1][3] A Organização Mundial de Saúde classifica os linfomas em cinco grupos principais, entre os quais um para o linfoma de Hodgkin.[6] No conjunto dos quatro grupos de linfoma não Hodgkin existem mais de 60 tipos específicos de linfoma.[7][8] O diagnóstico tem por base uma biópsia aos gânglios linfáticos ou à medula óssea.[1] Os exames imagiológicos permitem determinar o estádio do cancro.[1]
O tratamento depende se o linfoma é de crescimento lento ou rápido e se está limitado a uma área ou se se espalhou para várias áreas.[1] O tratamento consiste em quimioterapia, radioterapia, imunoterapia, terapia dirigida, transplante de células estaminais hematopoiéticas, cirurgia ou vigilância.[1] Quando o sangue se torna demasiado espesso devido aos anticorpos, pode ser necessária plasmaferese.[1] No entanto, a radioterapia e a quimioterapia aumentam o risco de nas décadas seguintes desenvolver outros cancros, doenças cardiovasculares ou problemas nervosos.[1]
Em 2015, cerca de 4,3 milhões de pessoas em todo o mundo tinham linfoma não Hodgkin. No mesmo ano, a doença foi a causa de 231 400 mortes.[4][5] Nos Estados Unidos, 2,1% da população é efatada pela doença em determinado momento da vida.[2] A idade de diagnóstico mais comum é entre os 65 e 75 anos de idade.[2] Nos Estados Unidos, a taxa de sobrevivência a 5 anos é de 71%.[2]
Classificação
Classificar o tipo de linfoma pode ser uma tarefa bastante complicada, por sua grande diversidade. Após o diagnóstico, a doença é classificada de acordo com a célula que o originou (linfócitos B ou T), a agressividade (indolente ou agressivo), o estágio (inicial, intermediário, avançado ou terminal), extensão (nodular ou difuso), pelo tamanho das células (pequenas, grandes ou mistas) e pelo . Estas informações são muito importantes para selecionar adequadamente a forma de tratamento do paciente, e estimar seu prognóstico.
Classificação por agressividade
Os linfomas indolentes (40% dos casos) têm um crescimento relativamente lento. Os pacientes podem apresentar-se com poucos sintomas por vários anos, mesmo após o diagnóstico. Entretanto, a cura nestes casos é menos provável do que nos pacientes com formas agressivas de linfoma. Esses últimos podem levar rapidamente ao óbito se não tratados, mas, em geral, são mais curáveis.[9]
Classificação Internacional de Doenças (CID-10)

Os Linfomas Não Hodgkin são divididos pela CID-10 em[10]:
- Linfomas Não Hodgkin folicular/nodular (C82)
- Linfomas Não Hodgkin Difuso (C83)
- Linfoma de Burkitt (C83.7)
- Linfomas de células T cutâneas ou periféricas (C84)
- Micose fungoide (C84.0)
- Doença de Sézary (C84.1)
- Linfoma não Hodgkin de outros tipos e de tipo não especificado (C85)
- Linfossarcoma (C85.0)
Nova classificação
_064_lores.jpg)
Em 2008 a OMS propôs que os linfomas sejam classificados em 5 grupos[11]:
- Neoplasias de linfócitos B maduras
- Neoplasias de linfócitos T ou Natural Killer (NK) maduras
- Neoplasias de precursores linfoides
- Linfoma de Hodgkin
- Perturbações linfoproliferativas associadas a imunodeficiência
Assim, o termo linfoma não Hodgkin deve ser substituído gradualmente por termos mais específicos conforme novos manuais são lançados.
Sinais e sintomas

Pode não ter sintomas por muitos anos. Quando existem sintomas (Fase B) incluem[12][13]:
- Aumento indolor dos linfonodos geralmente do pescoço, axilas e/ou virilha(sintoma mais comum);
- Aumento e dor abdominal (quando o linfoma está no abdômen)
- Dor no peito, tosse e respiração difícil (quando o linfoma está no tórax)
- Sudorese noturna excessiva e febre leve;
- Perda de peso e apetite inexplicada.
Causas
A causa é normalmente desconhecida, porém fatores de risco incluem: Os poucos conhecidos fatores de risco para o desenvolvimento de Linfomas Não Hodgkin são:
- Infecção viral (Vírus da hepatite C, HIV, HHV8, vírus da leucemia humana de células T, vírus Epstein-Barr[14]
- Infecção bacteriana por Helicobacter pylori (que causa úlceras gástricas)
- Doenças autoimunes
- Exposição a alguns pesticidas, solventes, fertilizantes com nitrato, herbicidas e inseticidas, geralmente através de rios e lagos em regiões rurais. Dentre os mais cancerígenos aparentemente estão os que contem bifenilos policlorados.
- Exposição a altas doses de radiação ou quimioterapia.
Prevenção
Assim como em outras formas de câncer, dietas ricas em verduras e frutas podem ter efeito protetor contra o desenvolvimento de Linfomas Não Hodgkin.[9]
Diagnóstico

Exames comumente utilizados incluem[15]:
- Clínicos: Apalpar gânglios inchados e outros sintomas
- Exames de imagem: tomografia computadorizada (TC), ressonância magnética ou tomografia por emissão de pósitrons (PET scan).
- Biópsia: de gânglio linfático e medula óssea.
- Exames de sangue: para contagem de células sanguíneas e identificar infecções virais.
Tratamento
Depende do tipo de linfoma, local, estágio, idade, imunidade e presença de sintomas. Geralmente envolve quimioterapia, radioterapia ou ambos. Imunoterapia radioativa também pode ser usada fazendo que anticorpos que ataquem as células cancerosas injetem a substância radioativa no tumor.[16]
Transfusão de sangue pode ser necessária quando o número de células sanguíneas reduz muito. Tratamentos com células-tronco podem ajudar a recuperar a medula óssea depois da quimioterapia.[16]
Epidemiologia
São diagnosticados aproximadamente 10.000 novos casos novos no Brasil por ano. É um pouco mais comum em homens e também atinge crianças. A mortalidade nos primeiros cinco anos depois do diagnóstico é de 39%, resultando em cerca de 4.000 mortes por ano. O número de casos praticamente duplicou nos últimos 25 anos, particularmente entre pessoas acima de 60 anos por razões ainda não esclarecidas. [17][18]
No mundo afeta cerca de 20 em cada 100.000 habitantes por ano. A frequência aumenta com a idade. Um pouco mais comum em homens. Em 2010 foi responsável pela morte de 210.000 pessoas.[19] Sendo que na segunda década de vida, a taxa é de quatro casos a cada 100 mil indivíduos, enquanto que na faixa dos 60 anos, os casos aumentam dez vezes, passando para 40 a cada 100 mil indivíduos.[20]
Ver também
Referências
- 1 2 3 4 5 6 7 8 9 10 11 12 13 14 15 «Adult Non-Hodgkin Lymphoma Treatment (PDQ®)–Patient Version». NCI. 3 de agosto de 2016. Consultado em 13 de agosto de 2016. Cópia arquivada em 16 de agosto de 2016
- 1 2 3 4 5 6 «SEER Stat Fact Sheets: Non-Hodgkin Lymphoma». NCI. Abril de 2016. Consultado em 13 de agosto de 2016. Cópia arquivada em 6 de julho de 2014
- 1 2 World Cancer Report 2014. [S.l.]: World Health Organization. 2014. pp. Chapter 2.4, 2.6. ISBN 9283204298
- 1 2 GBD 2015 Disease and Injury Incidence and Prevalence, Collaborators. (8 de outubro de 2016). «Global, regional, and national incidence, prevalence, and years lived with disability for 310 diseases and injuries, 1990–2015: a systematic analysis for the Global Burden of Disease Study 2015.». Lancet. 388 (10053): 1545–1602. PMC 5055577
. PMID 27733282. doi:10.1016/S0140-6736(16)31678-6 - 1 2 GBD 2015 Mortality and Causes of Death, Collaborators. (8 de outubro de 2016). «Global, regional, and national life expectancy, all-cause mortality, and cause-specific mortality for 249 causes of death, 1980–2015: a systematic analysis for the Global Burden of Disease Study 2015.». Lancet. 388 (10053): 1459–1544. PMC 5388903
. PMID 27733281. doi:10.1016/s0140-6736(16)31012-1 - ↑ «Adult Non-Hodgkin Lymphoma Treatment (PDQ®)–Health Professional Version». NCI. 1 de junho de 2016. Consultado em 13 de agosto de 2016. Cópia arquivada em 12 de agosto de 2016
- ↑ «Different types of non Hodgkin lymphoma». Cancer Research UK. Consultado em 13 de agosto de 2016. Cópia arquivada em 14 de agosto de 2016
- ↑ Bope, Edward T.; Kellerman, Rick D. (2015). Conn's Current Therapy 2016 (em inglês). [S.l.]: Elsevier Health Sciences. p. 878. ISBN 9780323355353. Cópia arquivada em 10 de setembro de 2017
- 1 2 http://www.inca.gov.br/conteudo_view.asp?id=457
- ↑ http://cid.ninsaude.com/capitulo/ii/c81-c96/#.VR4vQ9LtGkt
- ↑ Swerdlow, Steven H.; International Agency for Research on Cancer; World Health Organization (2008). WHO classification of tumours of haematopoietic and lymphoid tissues. World Health Organization classification of tumours 2 (4th ed.). International Agency for Research on Cancer. ISBN 9789283224310.
- ↑ http://www.mayoclinic.org/diseases-conditions/non-hodgkins-lymphoma/basics/symptoms/con-20027792
- ↑ http://www.healthline.com/health-slideshow/leukemia-lymphoma#7
- ↑ Maeda E, Akahane M, Kiryu S, Kato N, Yoshikawa T, Hayashi N, Aoki S, Minami M, Uozaki H, Fukayama M, Ohtomo K (2009). "Spectrum of Epstein-Barr virus-related diseases: A pictorial review". Japanese Journal of Radiology 27 (1): 4–19. doi:10.1007/s11604-008-0291-2. PMID 19373526
- ↑ http://www.mayoclinic.org/diseases-conditions/non-hodgkins-lymphoma/basics/tests-diagnosis/con-20027792
- 1 2 http://www.nlm.nih.gov/medlineplus/ency/article/000581.htm
- ↑ Registros de Câncer de Base Populacional (RCBP)
- ↑ http://www2.inca.gov.br/wps/wcm/connect/tiposdecancer/site/home/linfoma_nao_hodgkin
- ↑ IH NCI Surveillance, Epidemiology, and End Results Program. Posted to SEER website April 2014. SEER Stat Fact Sheets: Non-Hodgkin Lymphoma Page accessed Feb 26, 2015
- ↑ «Fatores de risco LNH». www.abrale.org.br. Consultado em 18 de março de 2016